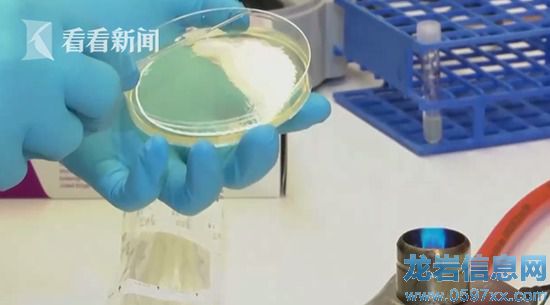

現在,大家出門拿個手機就好,想買什么都可以直接用手機支付。而在不久的未來,大家出門甚至手機都不用拿了。在身體內植入芯片變身"電子人",這聽起來像是科幻電影中的場景。但實際上,夢想已經開始照進現實。
隨著科技的發展,大家如今出門拿個手機就好,想買什么都可以直接刷手機。但是,在不久的未來,大家出門甚至手機都不用拿了。直接刷自己就好。瑞典一些企業正在試用"電子人"技術,只要在手中植入微芯片,揮揮手就能實現付款、甚至購買車票等目的。

在瑞典,搭乘國有鐵路公司SJ的火車,你甚至無需電子票,只要在讀卡器下揮揮手即可。SJ鐵路公司運營者斯特凡·拉伊介紹說:"這是一項新技術,目前尚處于起步階段,科技讓生活更加輕松。在我看來生活也更加有趣,不用出示票就能搭乘火車,這是一個新鮮的體驗,能為SJ公司吸引新乘客。"

原來,這是近場通訊技術的全新應用。要想實現如此便捷的購票,乘客首先要在手上植入微芯片,變身"電子人",微芯片被激活后將手放在距離讀卡器幾厘米外的位置,電磁波就會在兩個設備之間傳遞數據流,分分鐘識別乘客身份和網上購票記錄。

近場通訊技術并非一項新技術,在實行微芯片購票前,SJ鐵路公司已經利用這項技術檢驗車票,只需用智能手機掃描乘客購票記錄的條形碼,就能輕松驗票,極大提高了乘車效率。
實際上,近年來"電子人"在瑞典非常流行。斯德哥爾摩一家科技公司從2015年就開始向員工提供一項"福利":為員工免費提供微芯片植入服務。據了解,微芯片大小如米粒,植入位置位于手掌內靠近大拇指的地方,植入過程迅速、基本無痛。植入微芯片后,員工進出公司、使用打印機、中午點餐時都不需要刷卡,只要在掃描儀前揮揮手就可以。這家公司共有150人接受了這項"福利",他們覺得植入微芯片不光方便、實用,而且非常酷和時尚。